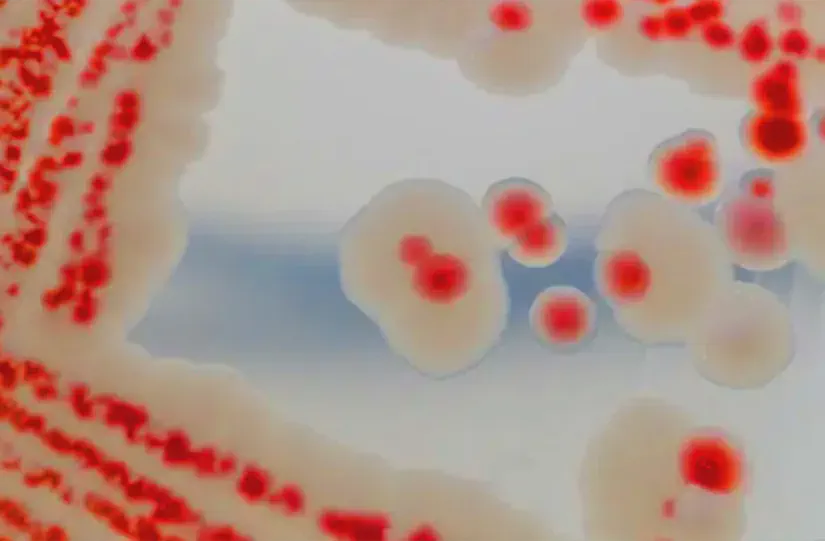

Mit rejt a fürdőszobai rózsaszín penész
A fürdőszobai rózsaszín baktérium rejtélye
A fürdőszobák titokzatos lakója, a rózszín penész, valójában csalóka névvel ellátott vendég. Nem gomba rejtőzik a csempék repedéseiben, hanem egy makacs baktériumhad sereglet, mely a nedvesség és a szappanmaradványok lakomáján ünnepel. Serratia marcescens a hivatalos neve, bár néha más, ritkább fajtársai is megjelennek a jelenetben.
Természetes környezetük a talaj és a víz, de könnyedén bevándorolnak otthonainkba is - egy nyitott ablakon, egy cipő talpán vagy akár a macska bundáján. Kedvelik a zuhanyfüggönyt, a csöpögő csapot, a kád sarkát, ahol nyálkás védőpajzsot építenek maguk köré. Ez a biofilm nemcsak erőssé teszi őket, de néha már-már művészi mintázatot visel a csempe fugáira.
Kezdetben alig láthatóak, ám ahogy szaporodnak, élénk prodigiozin pigmentet termelnek. Ez a vörös anyag szobahőmérsékleten még intenzívebbé válik, ám idővel sötétbarnává, majdnem feketévé sötétedhet - így tévesztve össze a hírhedt fekete penésszel. Történelmi tréfája, hogy egykor "vércsodákat" magyaráztak vele, ma pedig leginkább a háziasszonyok türelmét próbálja.
Bár egészséges emberekre általában veszélytelen, a gyengébb immunrendszerűeknek óvatosságra int. Kulcs a megelőzéshez: a rendszeres szellőztetés, a nedvesség visszaszorítása és a makacs tisztítás. Ne hagyd, hogy rózsaszín hadsereged legyen - bár a természet csodáit mindig érdemes csodálni, akkor is, ha épp a zuhanykabin sarkában telepszik meg.
A rózsaszín penész egészségügyi hatásai
A nedves zugokban, a fürdőszoba csempéin, a konyha sarkában bujkáló rózsaszín penész nem annyira kegyetlen, mint a fekete árnyéka, de attól még nem árt vele tisztában lenni. A fekete penész már-már hírhedt a tüdőt támadó fertőzéseiről, a fulladást hozó allergiákról, a légcsőszűkületről. A rózsaszín viszont – bár lágyabb – nem érdemel kevesebb figyelmet. Szereti a párás levegőt, s ha nem törődnek vele, gyorsan teret hódít.
Egészséges embereknél legfeljebb egy kis köhögést, tüsszögést okoz, de a gyengébbek – az asztmások, a nagypapák, a kicsik – jobban megszenvedhetik tőle. A rózsaszín penész köhögtet, megfázást hoz, gyomorgörcsöt, sőt, súlyos esetben még a szívet is megboríthatja. Ha pedig sebbe, horzsolásba jut, akár fertőzést is okozhat. Ezért fontos a tiszta kéz, a rendszeres takarítás, a gondos fertőtlenítés.
Még egy érdekesség: ez a rózsaszín folt nem is penész, hanem egy Serratia marcescens nevű, csínytevő baktérium. Szeret a zuhanfüggönyre telepedni, a csempefuga mélyébe bújni, sőt, még a fogkefetartót sem kerüli el. Hogy ne legyen otthon a házban, csökkenteni kell a párát, nyitni kell az ablakot, és rendszeresen dörzsölni kell a felületeket. Nem olyan gonosz, mint a fekete penész, de ha elhanyagolják, mégiscsak bajt okozhat – főleg azoknak, akiknek nincs erős az immunrendszerük.
Hatékony módszerek a fürdőszobai rózsaszín penész ellen
A háztartási fehérítő a penész elleni harc legyőzhetetlen fegyvere. Fertőtlenít, baktériumirtó, s a legmakacsabb foltok sem állják ellen. Kesztyűt fel, mert kemény a kémia – a bőrnek védelem kell.

Keverj két teáskanál fehérítőt fél liter vízbe, locold rá bőségesen, hagy egy órát töltenie a penészbontó munkával. Utána kefével vakard le, öblítsd vízzel, szárazra törölj – a nedvesség újra penészt szül.
Keményebb esetekben vízkőoldó spray és kemény kefe a megoldás, főleg, ha a penész a fugába vagy a vízkőbe rejtőzik. Spray fel, kefe le – így mindkettőnek vége.
A rózsaszín "penészre" – ami valójában ártalmatlan baktérium – a mosógép a válasz. Címkét nézni, mosható-e, ecet vagy szódabikarbóna az adaghoz – tisztít, szagtalanít.
Érdekesség: a rózsaszín penész nem penész, csak baktérium, a nedvességet szereti. Nem veszélyes, de csúnya – töröljük le, ne kísérletezzünk vele.





